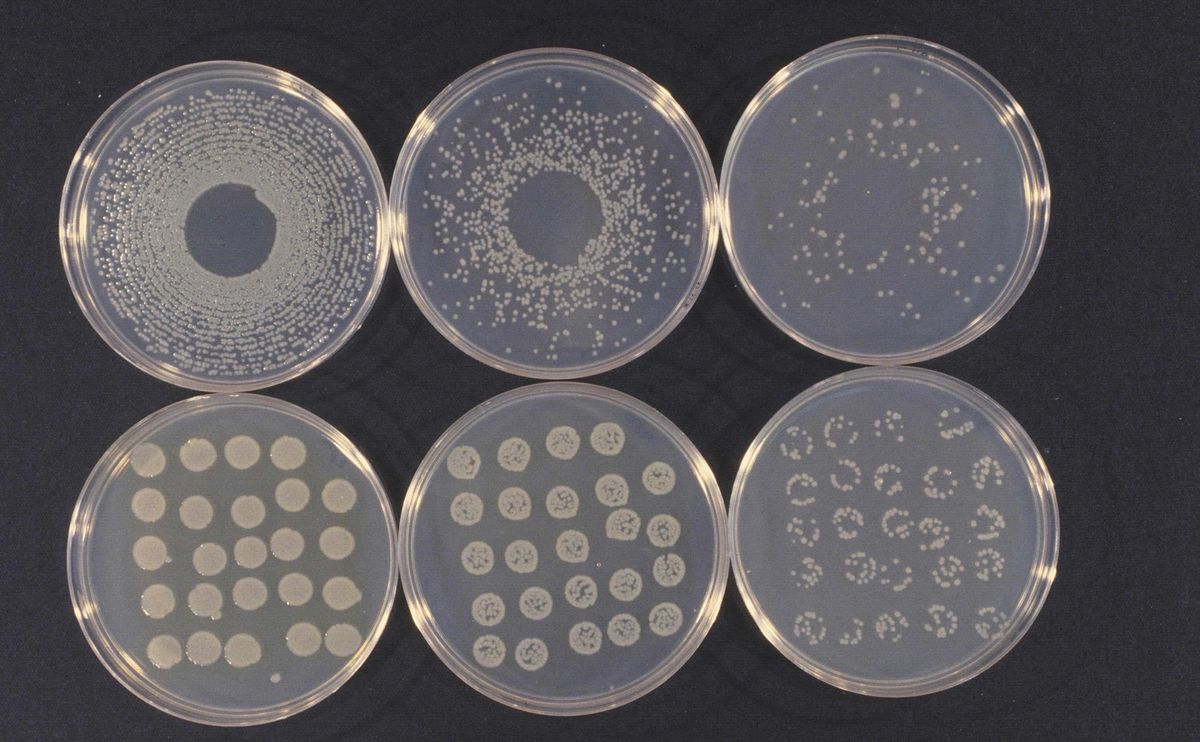
微生物菌 - 热门商品专区

生物菌

微生物菌名称及作用
图片尺寸400x267
图片都是什么菌 - 食品微生物检测 - 食品论坛 - powered by discuz!
图片尺寸1080x1440
微生物技术将会成功推动我国生态农业的发展和成熟
图片尺寸300x200
生物菌对作物和土壤的功效
图片尺寸360x200
各种微生物菌在培养基下的图片#农业种植 #心系三农服务三农 - 抖音
图片尺寸1159x1080
微生物菌名称及作用
图片尺寸1200x800
生物菌时代枯草芽孢杆菌的神奇之处
图片尺寸381x334
必看科普:生物菌为何能解决棘手的土壤难题?
图片尺寸586x431
生物菌图片
图片尺寸457x300
常见生物菌的种类及作用
图片尺寸640x506
各种生物菌的效果,棚友必读
图片尺寸640x558
微生物菌 - 热门商品专区
图片尺寸1200x742
常见生物菌的种类及作用
图片尺寸640x397
必看科普生物菌为何能解决棘手的土壤难题69
图片尺寸585x553
农业用各种微生物菌对植物营养的贡献
图片尺寸640x480
生活史绘制臭豆腐霉菌的单根菌丝及孢子图黏菌是什么生物菌体生长营养
图片尺寸658x987
微生物菌有多强大种植水产养殖都离不开它一
图片尺寸375x300
收藏24种污水处理微生物菌相及指导意义
图片尺寸493x427
农业用各种微生物菌对植物营养的贡献
图片尺寸640x715
嘉定便宜的复合生物菌技术
图片尺寸500x500